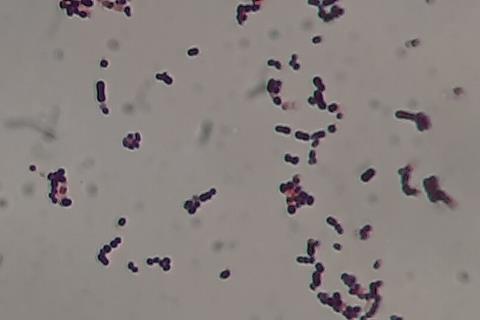
Streptococcus_agalactiae_Gram_staining_of_culture

Researchers at the University of Maine have discovered that a common interaction between a bacterium and a fungus may significantly increase the risk of severe and potentially fatal infections in newborns, while also making standard treatments less effective.
About one-fifth of healthy people worldwide carry bacteria known as Streptococcus agalactiae (group B strep or GBS) in their bodies, but it can cause serious infections in those who are immunocompromised, including newborns, pregnant women and seniors.
If newborns are exposed to GBS, they can contract meningitis, which can be fatal or cause lifelong neurological complications.
A new study reveals that when GBS interacts with Candida albicans (C. albicans), a fungus and common culprit behind yeast infections, GBS is more likely to spread disease and become harder to treat in newborns. Infection by both microbes reduces the effectiveness of existing GBS treatments.
“Our hope is that our findings will aid clinicians by providing new insight into treatment decisions when they examine pregnant women for the presence of GBS prior to delivery, to include looking for co-infections with C. albicans,” said study co-author Melody Neely, associate professor and chair of UMaine’s Department of Molecular and Biomedical Sciences.
Mother to baby
Nearly one-third of women around the globe have some C. albicans in their genital tract, and GBS is found in 10-30% of pregnant women. Both can exist in parts of the gastrointestinal and reproductive systems, and be transferred from mother to baby in utero or during delivery. Previous research has shown a common association and co-infection by these microbes in patients.
To examine how these organisms interact with each other, UMaine researchers and their colleagues grew cultures of GBS and C. albicans in the same culture tubes and in separate tubes. They found that GBS cells grow faster when they reside in the same environment as C. albicans. The two microbes don’t even need to interact with each other for C. albicans to enhance GBS growth, according to researchers.
Researchers tested the infectious strength and drug resistance of GBS when exposed to C. albicans by injecting both simultaneously into the larvae of zebrafish. These paperclip-sized fish share genetic similarities to humans and have unique traits that allow scientists to watch disease processes and cellular development in real time. The team found that GBS was more infectious when combined with C.albicans in the larvae. It was also more resistant to antibiotic treatments.
Co-infection risk
The study was the first to test how infectious and drug resistant GBS can be through a co-infection with C.albicans. The results are outlined in a paper published in the journal Infection and Immunity from the American Society for Microbiology.
“While current treatments for the presence of GBS in pregnant women is to give intravenous antibiotics several hours prior to delivery, if C. albicans is also present, the antibiotic may not be as effective and therefore, not able to clear the GBS,” Neely said.
While coinfection with C. albicans can make GBS stronger, their ability to influence each other may depend on the environment in which they grow and to what extent nutrients like amino acids and sugars are available. Researchers found that nutrient availability, which most likely impacts gene expression, impacts how these microbes interact with each other.
Important concern
“These findings raise an important concern of whether individuals carrying both the bacteria and the fungi are at greater risk for dangerous disease, a question we would like to answer in the future,” said Robert Wheeler, professor of microbiology who co-authored the study.
UMaine alumna and former adjunct instructor Kathryn Patenaude, who now teaches at St. Joseph’s College of Maine, led the study in collaboration with Neely, Wheeler and other former and current graduate student researchers.
Their publication follows the recent expansion of UMaine’s zebrafish lab in Hitchner Hall. Zebrafish are driving some of UMaine’s most advanced biomedical discoveries, and the lab draws faculty and students who want to study muscular dystrophy, cancer, infections, toxins and other human health challenges.







No comments yet